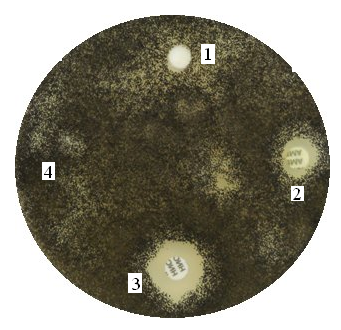

Древесина до настоящего времени остается одним из самых распространенных и наиболее перспективных экологичных строительных и конструкционных материалов многофункционального назначения. Несмотря на огромную значимость в народном хозяйстве и быту, данный природный материал обладает рядом недостатков [1]. При хранении и эксплуатации древесных материалов и изделий, в них со временем неизбежно протекают процессы старения и разрушения, в которые значительный вклад вносит явление биокоррозии. Будучи органической, по своей природе, древесина служит питательной средой для разного рода микроорганизмов, грибов и насекомых.
Для деревянных конструкций в строительстве наиболее опасной принято считать биодеструкцию, вызванную грибами. Это приводит к потере несущей способности конструкций, обрушению или деформации, при наступлении которой исключается возможность дальнейшей эксплуатации. Кроме того многие виды грибов патогенны или условно патогенны по отношению к человеку и животным, и могут вызывать многочисленные, иногда даже смертельные заболевания.
Наиболее эффективным методом защиты древесины от биологических разрушающих факторов является ее химическая обработка средствами, обладающими биоцидной активностью. Выраженными антисептическими свойствами обладают многие соединения бора, являющиеся недорогими и доступными.
Наряду с экологической безопасностью, эффективный антисептик должен обладать высокой токсичностью по отношению к биологическим вредителям, быть химически стойким, хорошо проникать в древесину, не иметь неприятного запаха, быть безвредным для человека и животных, не снижать физико-механических свойства древесины и не вызывать коррозийных процессов в металлических крепежных деталях.
В значительной степени указанными свойствами обладают многие соединения бора и фосфора, в частности борная кислота.
Известные составы на водной основе, в том числе содержащие соединения бора и фосфора, имеют сравнительно низкую защищающую способность, так как легко вымываются с поверхности и из внутренних слоев древесины, поскольку недостаточно прочно связываются с веществами древесины.
Значительная часть применяемых в современной практике препаратов обладает различными недостатками, например, высокими нормами расхода и низкой устойчивостью в окружающей среде или, напротив, излишней персистентностью, токсичностью для растений, животных и человека, коротким сроком действия, обусловленным быстрой вымываемостью и выветриванием из защищаемой древесины.
Известные огнебиозащитные композиции выпускаются в форме лаков, красок и паст, пригодных лишь для поверхностной обработки древесных материалов, что также является недостатком, поскольку для древесины необходима глубокая пропитка с повышенной степенью фиксации обрабатывающей композиции на внутренних волокнах древесины. Производство и использование таких средств связано с применением дорогостоящих, часто огнеопасных и токсичных органических растворителей.
Задача эффективной фиксации антисептических веществ на древесной матрице может быть достигнута путем введения в состав композиций водорастворимых добавок имеющих олигомерную основу, которые посредством физико-химического взаимодействия с компонентами образуют достаточно прочные интерполимерные комплексы. При этом часто указанные добавки помимо биоцидной активности проявляют также свойства антипиренов, что является положительным моментом. Таким комплексным действием обладают в частности составы, содержащие соединения фосфора и азота образующиеся при химической деструкции отходов полиэтилентерефталата (ПЭТФ), являющихся самыми массовыми твердыми бытовыми отходами в России.
Целью данной работы является разработка нового средства защиты древесины комплексного действия на водной основе с использованием отходов ПЭТФ и доступных химических реагентов, предназначенного для глубокой пропитки различных деревянных конструкций.
Нами был разработан ряд средств для комплексной защиты древесины, в частности «NORWOOD ЕСО» по технологически доступной схеме, исключающей стадии выделения и очистки промежуточных и конечных продуктов. Основными активными компонентами являются N-(2-оксиэтил)амиды низкомолекулярных фрагментов деструктированного ПЭТФ структуры, приведенной на рисунке 1, где n колеблется от 1 до 5, дополнительно модифицированные производными борной кислоты.

Рисунок 1 – Структура деструктированного ПЭТФ
Исследование проводили на образцах сосновой древесины. В работе были использованы следующие тест-культуры микроорганизмов.
Микроскопические грибы (плесневые) – Fusarium culmorum, Trichoderma viridae, Aspergillus niger, которые обладают рядом ферментных систем, являются активными деструкторами органического вещества в природе, являются активными деструкторами древесины (Fusarium culmorum и Trichoderma viridae способны к деструкции, как целлюлозы, так и лигнина, Aspergillus niger преимущественно обладает целлюлолитической активностью.)
Питательные среды:
Среда Чапека-Докса жидкая: калий фосфорнокислый однозамещенный - 0,7 г; калий фосфорнокислый двузамещенный 3-водный - 0,3 г; магний сернокислый 7-водный - 0,5 г; натрий азотнокислый - 2,0 г; калий хлористый - 0,5 г; железо (II) сернокислое 7-водное - 0,01 г; сахароза - 30 г; вода дистиллированная - до 1000,0 см3;
Среда Чапека-Доска плотная: калий фосфорнокислый однозамещенный - 0,7 г; калий фосфорнокислый двузамещенный 3-водный - 0,3 г; магний сернокислый 7-водный - 0,5 г; натрий азотнокислый - 2,0 г; калий хлористый - 0,5 г; железо (II) сернокислое 7-водное - 0,01 г; сахароза - 30 г; агар – 20 г; вода дистиллированная - до 1000,0 см3;
Диски с антибиотиками: цефтриаксон (30 мкг), тетрациклин (30 мкг), гентамицин (120 мгк), амфотерицин В ( 40 мкг), нистатин (80 ЕД), флуконазол (40 мкг).
Обработке опытным биоцидом подвергался опил на который предварительно были подсажены культуры белой (Fusarium culmorum) и черной (Aspergillus niger) плесени первой, второй группы соответственно, выращенные на питательных средах, взятые из коллекции кафедры биотехнологии Вятского Государственного Университета. Для приготовления суспензии спор использовали культуры грибов возрастом от 14 до 28 суток, считая с момента пересева. Суспензию с концентрацией спор 1 млн/см3 готовили отдельно для каждого вида гриба путем разведения исходной суспензии, полученной смывом конидий (спор) гриба в сосуды, содержащие 50 см3 дистиллированной стерильной воды. Количество спор грибов в рабочей суспензии подсчитывали при помощи счетной камеры Горяева. За основу методики проведения биологических испытаний были взяты указания [2], согласно которым испытания проводятся на грибах, принадлежащим к трем группам.
Образующие плесень микроорганизмы подсаживали кроме того на образцы древесины в виде брусков, один из которых был предварительно пропитан опытной композицией. Действие композиций визуально сравнивали с такими же образцами древесины, не подвергнутыми какой-либо обработке. Обработку образцов древесины проводили путем пропитки при комнатной температуре в течение одних суток при модуле ванны 1:10. После удаления избытка пропиточного раствора обработанный материал подвергали биологическим испытаниям.
Процент адсорбировованных защитных веществ на волокнах древесины определяли по изменению массы образцов до и после обработки опытным составом. Перед взвешиванием образцы высушивали и кондиционировали в атмосфере с постоянной влажностью.
Предполагается, что разрушение полимерных цепей ПЭТФ происходит в данном случае за счет протекания преимущественно процесса аминолиза сложноэфирных групп полимера при нуклеофильной атаке молекул аминоспирта, содержащих как гидроксильную, так и первичную аминогруппы [3]. Протекание процесса химической деструкции ПЭТФ под действием моноэтаноламина может быть представлено общей схемой, изображенной на рисунке 1.
При действии на ПЭТФ триэтаноламина протекают несколько иные процессы, поскольку этот аминоспирт не содержит в своей структуре реакционноспособных аминогрупп. Третичные аминогруппы не могут выступать в роли реакционных центров, за счет которых осуществляется реакция аминолиза, как в случае с моноэтаноламином, однако в молекуле триэтаноламина присутствуют три гидроксильные группы, также являющиеся нуклеофильными центрами.

Рисунок 1 – Протекание процесса деструкции ПЭТФ под действием МЭА
В случае деструкции макромолекул ПЭТФ под действием ТЭА может происходить только аналогичная реакция алкоголиза с участием гидроксильных групп, в результате которой образуются β-аминозамещенные концевые фрагменты (Рис. 2).

Рисунок 2 – Протекание процесса деструкции ПЭТФ под действием ТЭА
Концевые азотсодержащие группы, включенные в модифицированные молекулы ПЭТФ, содержат еще свободные гидроксильные группы и могут далее участвовать в реакции алкоголиза, аналогично молекулам триэтаноламина. При этом образуются олигомерные молекулы как линейной, так и разветвленной структуры, включающие фрагменты аминоспиртов.
Наличие неподеленных электронных пар на атомах азота позволяет полученным промежуточным продуктам вступать в реакцию с кислотными реагентами по типу нейтрализации. В нашем случае основным кислотным реагентом выступает борная кислота, несущая на себе основную функцию биоцида. При этом возможно также образование бороазотных комплексов по донорно-акцепторному механизму с участием вакантной орбитали атома бора [4].
В условиях взаимодействия с компонентами древесины эти вещества могут образовывать прочные ассоциаты как с древесными полимерами (целлюлозой и лигнином), так и с молекулами деструктурированного ПЭТФ [5]. Высокая прочность интерполимерных комплексов может быть объяснена образованием поперечных связей в слоях модифицированной древесины за счет возникновения гидролитически стойких комплексных соединений по атомам бора. При этом донорно-акцепторные связи возникают за счет перехода неподеленных электронных пар атомов кислорода гидроксильных и других функциональных центров древесины на вакантные р-орбитали атома бора. Следствием такого физико-химического взаимодействия является пониженная вымываемость защищающих древесину веществ при воздействии влаги различного происхождения и соответственно повышенная длительность защиты.
Результаты биологических испытаний приведены на рисунках 3 – 5.
Как видно из рисунков 3, 4 активные вещества опытных составов проявили достаточно высокую противоплесневую (фунгицидную) эффективность на питательных средах, сравнимую с использованными антибиотиками.

Рисунок 3 – Действие различных биоцидов на культуру Trichoderma viridae: 1 – опытный состав, 2 - цефтриаксон (30 мкг), 3 - тетрациклин (30 мкг), 4 - гентамицин (120 мгк)
Рисунок 4 – Действие различных биоцидов на культуру Aspergillus niger: 1 – опытный состав, 2 - амфотерицин В ( 40 мкг), 3 - нистатин (80 ЕД), 4 - флуконазол (40 мкг).
На рисунках 5 а, 5 б изображены образцы древесины в виде брусков, один из которых подвергнут защитной обработке (рисунок 5б); второй образец является контрольным (рисунок 5а). Рост плесени на поверхности обработанного бруска практически полностью подавлен, в то время как на необработанном бруске можно наблюдать интенсивное зарастание.
Аналогичная картина наблюдается в случае испытаний древесины в виде опила, на поверхности которого при отсутствии обработки образуется множество колоний, как в случае белой, так и черной культур плесневых грибов.

а – не обработанный опытной композицией; б – обработанный опытной композицией
Рисунок 5 – Брусок древесины с культурами Aspergillus niger и Trichoderma viridae
Таким образом, во всех случаях вещества опытной композиции оказали существенное подавляющее действие на рост выбранных для исследований микроорганизмов.
Огнезащитную эффективность опытных составов определяли путем оценки потери массы образцов древесины обработанных испытываемыми пропиточными составами, при воздействии пламени в условиях благоприятствующих аккумуляии тепла в соответствии с ГОСТ 16363-98. Обработанные образцы древесины подвергали испытанию на водостойкость. Для этого их выдерживали в воде в течение 72 часов при модуле ванны 1:10, после чего испытывали их огнестойкость. Результаты испытаний приведены в таблице 1.
Таблица 1
|
Номер образца |
Общее поглощение, кг/м3 |
Средняя потеря массы образца |
|
|
Г |
% |
||
|
Состав № 1 |
67,27 |
2,16 |
2,01 |
|
Состав № 2 |
127,85 |
1,77 |
1,47 |
|
После испытания на водостойкость |
|||
|
Состав № 1 |
|
7,05 |
5,97 |
|
Состав № 2 |
|
4,76 |
5,68 |
На основании результатов испытания полученному средству защиты древесины можно присвоить первую группу огнезащитной эффективности. После испытания на водостойкость показатели убыли массы образцов изменяются незначительно, что подтверждает гидролитическую устойчивость комплекса древесины с введенными в нее огнезащитными веществами. При этом антипирены, подвергнутые вымыванию водой, продолжают эффективно сохранять свои огнезащитные свойства по отношению к древесине.
Выводы
Получено новое средство защиты древесины от ряда биологических разрушающих факторов, в частности плесеней, сочетающее в себе антипиренную эффективность. Состав получен в виде водного раствора без использования органических растворителей по технологически доступной схеме, исключающей стадии выделения и очистки промежуточных и конечных продуктов.
Использование олигомерных компонентов, получаемых химической деструкцией ПЭТФ, позволило повысить степень фиксации биоцидных веществ на волокнах древесины за счет образования интерполимерных комплексов.
На основании повышенной гидролитической устойчивости данных комплексов можно сделать предположение о долговечности защитного действия разработанного фунгицида.
Показана сравнительно высокая фунгицидная активность полученного средства по отношению к древесине, проявляющаяся при невысокой концентрации пропиточного состава, сравнимая с традиционными антибиотиками.
Таким образом, показана возможность получения эффективных огнезащитных составов на водной основе, которые могут быть использованы для обработки как внутренних скрытых, так и наружных, подверженных атмосферным осадкам, деревянных конструкций жилых, производственных, административных и других типов объектов.

Olga Kislicina